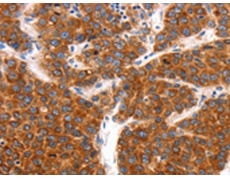
一抗

|
Background: |
The Shaker gene family of Drosophila encodes components of voltage-gated potassium channels and is comprised of four subfamilies. Based on sequence similarity, this gene is similar to one of these subfamilies, namely the Shaw subfamily. The protein encoded by this gene belongs to the delayed rectifier class of channel proteins and is an integral membrane protein that mediates the voltage-dependent potassium ion permeability of excitable membranes. Several transcript variants encoding different isoforms have been found for this gene. |
|
Applications: |
ELISA, IHC |
|
Name of antibody: |
KCNC2 |
|
Immunogen: |
Synthetic peptide of human KCNC2 |
|
Full name: |
potassium voltage-gated channel, Shaw-related subfamily, member 2 |
|
Synonyms: |
KV3.2 |
|
SwissProt: |
Q96PR1 |
|
ELISA Recommended dilution: |
1000-2000 |
|
IHC positive control: |
Human liver cancer and Human colon cancer |
|
IHC Recommend dilution: |
150-500 |

 購物車
購物車 幫助
幫助
 021-54845833/15800441009
021-54845833/15800441009